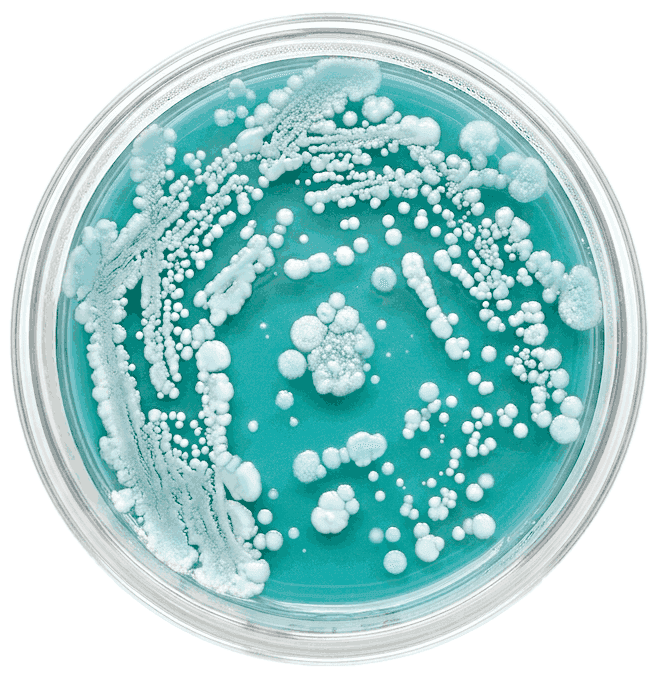

2,000+ Cases Analyzed
Microbiologist & Naturopath Team

The rest stays hidden. Parasites, inflammatory markers and specific bacterial strains that are driving your symptoms.
You can get test results that say everything is 'normal' while the real cause of your symptoms is still right there.

The same advanced technology used
in research laboratories.
It maps your entire gut ecosystem: bacteria, parasites, yeasts and inflammation markers like calprotectin.

Which imbalances are actually causing your
symptoms - and which ones are irrelevant
Whether the probiotics you’re already taking
are helping or making things worse
What to address first, second, and third -
because the sequence matters
How to build a plan that fits your life,
not just a generic protocol
Don’t take our word for it. Here’s what our clients have to say.
…The depth of information regarding microbiome and dna testing was incredible and highlighted areas to which I had accepted as normal function and behavior.
Amandas consultations helped decypher the vast amount of information and pin point specific areas that needed addressing.
Declan McDonald
Living remotely, I wasn’t looking for a local clinic—I was desperate for someone who could help me online. That’s when I found Prana Thrive and Amanda—and she changed my life.
We started with microbiome testing, and the results came with a comprehensive report. I followed Amanda’s advice from day one. I've continued using the recommended products intermittently for the past five years. Amanda didn’t just help with the gut health; she helped reduce my stress and supported me in creating a sustainable way to live flare-free.
Hayley Brett
I reached out to Prana Thrive after a family member recommended them and I could not be happier with the service provided! I completed a full gut health plan and am so happy with my results! Amanda was able to tailor the plan to fit in with my busy family life. We also received our supplements extremely fast! Thank you so much Amanda you have changed my life!
Adele M
… I would highly recommend Amanda and her team if you are looking for life changing results.
Kerry White

What your symptoms suggest about what’s happening in your gut microbiome
Why the approaches you’ve tried
haven’t worked and what to do differently
Which type of microbiome testing is right
for your situation
Whether our approach is the right fit for you (and we’ll tell you honestly if it’s not)